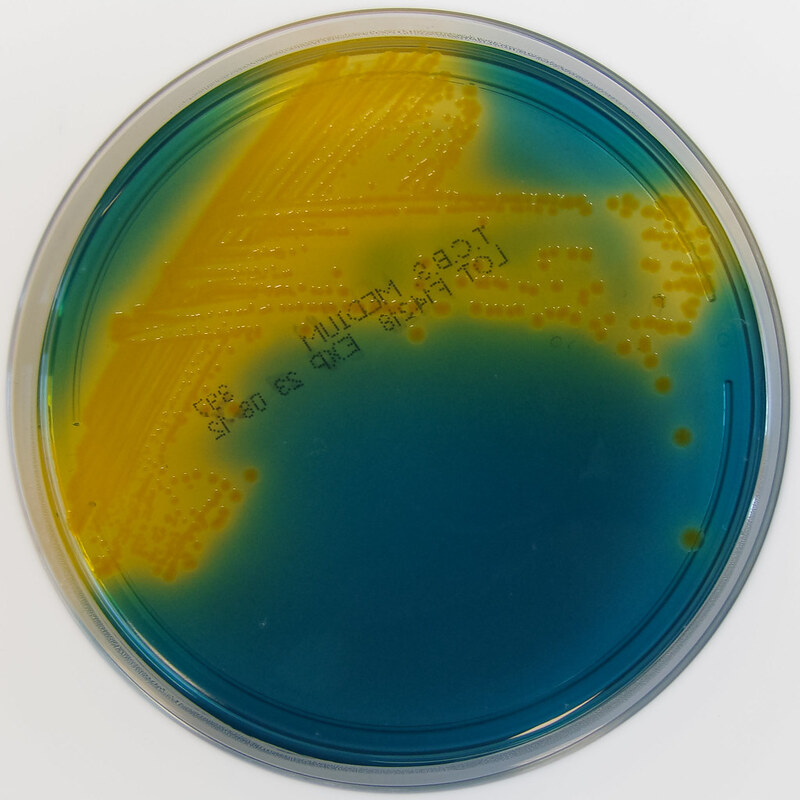
Маленькие молекулы с двоякой функцией

Малая РНК и малый белок регулируют метаболизм холерных бактерий и производство холерного токсина.
Исследователи Университета Фридриха Шиллера в Йене изучают, как холерным вибрионам удается нарушать кишечный баланс и одновременно вырабатывать патогенный токсин. В текущем выпуске журнала EMBO они представили ранее неизвестный молекулярный механизм производства холерного токсина. Центральное место в этом механизме занимает малая РНК (sRNA) в сочетании с небольшим белком. "Малые рибонуклеиновые кислоты и малые белки часто игнорировались в прошлом, но они играют важную роль в физиологии микроорганизмов", - объясняет профессор общей микробиологии Йенского университета Кай Папенфорт. "Молекулярные механизмы функционирования этих малых молекул до сих пор изучены не полностью".
В своей работе Папенфорт и его коллеги смогли показать, что молекула РНК, названная VcdRP (Vibrio cholerae dual RNA and protein), вмешивается на двух различных уровнях в метаболизм возбудителя холеры и таким образом контролирует его вредное воздействие. "С одной стороны, молекула VcdRP, подавляет производство холерного токсина. С другой стороны, эта маленькая рибонуклеиновая кислота одновременно берет на себя роль частицы генетической информации и кодирует небольшой регуляторный белок", - говорит Папенфорт. Этот белок, в свою очередь, активирует центральный метаболический путь, который преобразует углерод из пищи в энергию и строительные блоки биосинтеза, такие как аминокислоты".
"Наша работа показывает, что производство токсинов и, следовательно, вызывающие болезнь свойства возбудителя холеры напрямую связаны с его метаболизмом", - говорит Папенфорт. Впервые исследователям удалось выявить sRNA с такой двойной функцией у холерных вибрионов. Их выводы создают важную основу для разработки новых способов борьбы с холерой. В то же время новые данные могут быть полезны в биотехнологических приложениях с микроорганизмами, которые используют тот же молекулярный механизм, что и РНК с двойной функцией.
Исследование позволяет понять фундаментальные механизмы микробных сообществ и разработать инновационные терапевтические подходы.